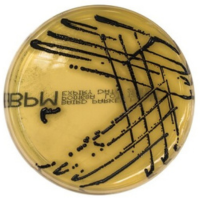
Baird_Parker_Medium_gotowa_pożywka_do_izolowania_Staphylococcus_aureus_Bestlabs.png

Baird Parker Agar gotowa selektywna pożywka do izolowania Staphylococcus aureus
• Opakowanie: 10 szt.
• Płytka: 90 mm
• Do izolowania: Staphylococcus aureus
 Opis
Opis
Baird Parker Agar gotowa pożywka do izolowania Staphylococcus aureus
Baird-Parker Agar marki Oxoid to specjalistyczne podłoże selektywno-różnicujące przeznaczone do Staphylococcus aureus wykrywanie, izolacji oraz oznaczania liczby tego drobnoustroju w próbkach żywnościowych, środowiskowych i wybranych materiałach klinicznych. Produkt stanowi ważny element wyposażenia laboratoryjnego w obszarze mikrobiologia żywności, wspierając analizę próbek, kontrolę jakości, procedury GLP, GMP, SOP oraz rejestrację wyników w systemach LIMS.
Czym jest Baird-Parker Agar
Jak działa Baird-Parker Agar
Baird-Parker Agar to agar selektywny gronkowiec, opracowany do odzysku i wstępnej identyfikacji Staphylococcus aureus. Dzięki połączeniu substancji selektywnych i diagnostycznych podłoże umożliwia wzrost docelowych kolonii przy jednoczesnym ograniczeniu rozwoju większości mikroflory towarzyszącej.
Zastosowanie w izolacji Staphylococcus aureus
Zastosowanie
Podłoże znajduje zastosowanie w badaniach żywności, próbek środowiskowych oraz materiałów kontrolnych, gdzie wymagane jest wiarygodne Staphylococcus aureus wykrywanie. Produkt wspiera rutynową kontrolę jakości w zakładach spożywczych, farmaceutycznych, kosmetycznych oraz w laboratoriach wykonujących badania sanitarne i walidacyjne.
Mechanizm selektywności i różnicowania
Znaczenie analityczne
Substancje selektywne, takie jak glicyna, chlorek litu i tellurynian potasu, hamują wzrost wielu bakterii towarzyszących, a żółtko jaja pełni funkcję diagnostyczną. Pirogronian sodu wspiera regenerację komórek uszkodzonych. Dzięki temu podłoża selektywno-różnicujące tego typu umożliwiają czytelny odczyt kolonii typowych dla gronkowca złocistego.
Interpretacja wyników - kolonie typowe
Jak rozpoznać Staphylococcus aureus
Typowe kolonie Staphylococcus aureus na Baird-Parker Agar są szaro-czarne, błyszczące i otoczone przejrzystą strefą. W dalszej inkubacji mogą pojawiać się również nieprzezroczyste otoczki. Taki obraz kolonii wspiera szybką interpretację wyników, choć w wybranych przypadkach zalecane jest potwierdzenie dodatkowymi testami, np. koagulazowym.
Specyfikacja techniczna Baird-Parker Agar
Kluczowe cechy i parametry techniczne
- Rodzaj podłoża - agar Bairda-Parkera.
- Format - monopłytka 90 mm.
- Gabarwa napełnienia - 19,0 ± 2,0 g lub 17,5 g ± 5%.
- Wygląd - kremowe, półprzezroczyste podłoże.
- pH - 6,8 ± 0,2.
- Opakowanie - 10 płytek owiniętych folią. Dlaczego to ważne: wspiera stabilność medium i ogranicza ryzyko kontaminacji.
- Przechowywanie - 6°C do 12°C.
- Termin przydatności - do 14 tygodni lub 6 tygodni, zależnie od specyfikacji partii.
- Miejsce produkcji - Niemcy.
- Zgodność - ISO 6888-1.
Skład typowy podłoża Baird-Parker Agar
- Trzustkowy hydrolizat kazeiny - 10,0 g/l
- Ekstrakt wołowy - 5,0 g/l
- Ekstrakt drożdżowy - 1,0 g/l
- Pirogronian sodu - 10,0 g/l
- Glicyna - 12,0 g/l
- Chlorek litu - 5,0 g/l
- Tellurynian potasu - 0,1 g/l
- Agar - 20,0 g/l
- Żółtko jaja - 50,0 ml/l
Podany skład typowy ma charakter informacyjny. Szczegółowe parametry jakościowe oraz dane partii określane są każdorazowo w dokumentacji producenta.
Zastosowanie w przemyśle spożywczym i diagnostyce
Ergonomia i trwałość
Gotowe płytki ułatwiają organizację pracy w laboratoriach o wysokiej przepustowości i wspierają powtarzalność wyników. Produkt znajduje szerokie zastosowanie w mikrobiologia żywności, badaniach sanitarno-epidemiologicznych, walidacji procesów oraz w jednostkach nadzoru jakości, które wykorzystują standaryzowane procedury i urządzenia pomiarowe.
FAQ - Baird-Parker Agar i agar selektywny gronkowiec
Jak rozpoznać Staphylococcus aureus?
Typowe kolonie są szaro-czarne, błyszczące i zwykle otoczone przejrzystą strefą, co wspiera ich wstępną identyfikację na podłożu.
Jak inkubować próbki?
Warunki inkubacji należy dobrać zgodnie z procedurą laboratorium i normą metodyczną. Czas oraz temperatura inkubacji zależą od przyjętej procedury badawczej i rodzaju próbki.
Czym różni się od innych podłoży selektywnych?
Baird-Parker Agar łączy selektywność wobec mikroflory towarzyszącej z różnicowaniem kolonii dzięki obecności tellurynu i żółtka jaja, co ułatwia ocenę typowych kolonii Staphylococcus aureus.
Do jakich próbek najlepiej stosować to podłoże?
Podłoże najlepiej sprawdza się w badaniach żywności, próbek środowiskowych i materiałów kontrolnych, gdzie wymagane jest oznaczanie liczby lub izolacja Staphylococcus aureus.
Gdzie uzyskać wsparcie techniczne?
Wsparcie techniczne dotyczące doboru pożywek Oxoid i badań w kierunku gronkowca złocistego można uzyskać w Argenta Poznań.
Potrzebujesz pomocy w dobraniu idealnego produktu dla Twojego laboratorium? Informacje na ten temat znajdziesz tu:
W powyższym linku znajdą Państwo bazę aktualnych certyfikatów firmy OXOID. Wystarczy wpisać numer LOT zamówionej przez Państwa partii, w celu uzyskania odpowiedniego certyfikatu.
 Koszty dostawy
Cena netto, nie zawiera podatku
Koszty dostawy
Cena netto, nie zawiera podatku
darmowa i wygodna wysyłka
już od 800 zł netto
Najwyższa jakość
produktów potwierdzona certyfikatami
Zakupy 24h na dobę
wygodne i bezpieczne
bezpłatna konsultacja
z ekspertem online